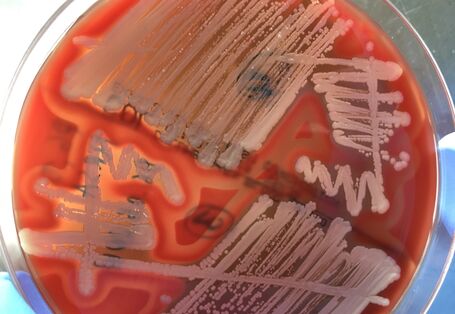
Foto: Methicillin resistente Staphylococcus aureus aus Schweineabstrichen isoliert auf einer Blut-Agar-Platte

Bild vom | Zuletzt aktualisiert am
Aus Umweltsicht wäre es positiv, wenn der E-Scooter den Umstieg vom Auto auf den ÖPNV erleichtert.

… Aus Umweltsicht wäre es positiv, wenn der E-Scooter den Umstieg vom Auto auf den ÖPNV erleichtert. Quelle: Manuela Weber / Umweltbundesamt Die … Elektrotretroller … Aus Umweltsicht wäre es positiv, wenn der E-Scooter den Umstieg vom Auto auf den ÖPNV erleichtert. …